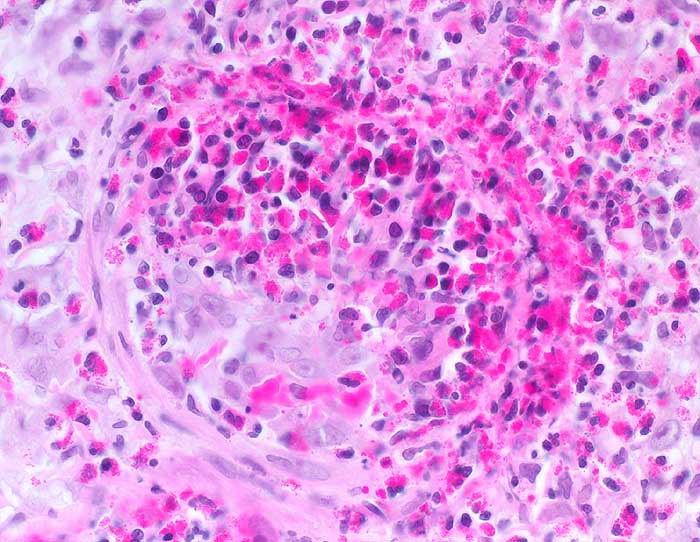

PathoPic – image database / PathoPic ID 6380 - Churg Strauss Vaskulitis
de
Diagnose
Churg Strauss Vaskulitis
Diagnose Gruppe
Systemerkrankung/Immunpathologie
Topographie
Lunge
Topographie Gruppe
Lunge, Mediastinum mit Thymus
Beschreibung
Ausgeprägte von eosinophilen dominierte destruktive Gefässwandentzündung.
Klinik
V.a. Churg-Strauss bei diffuser Lungeninfiltration bds, mehrjährigem Asthma mit aktueller Bluteosinophilie und IgE-Erhöhung. St.n. Therapie mit Leukotrien-Rezeptorantagonisten. Verschlechterung des Asthmas unter Therapie. -> diagnostische Thorakotomie.
Kommentar
Der morphologische Befund ist klassisch für ein Churg-Strauss-Syndrom und passt auch zu der Anamnese eines mehrjährigen Asthmas mit aktueller Bluteosinophilie und IgE-Erhöhung. Der Befund könnte im Zusammenhang stehen mit einer ca. seit drei Monaten bestehenden Therapie mit Leukotrien-Rezeptorantagonisten, welche nach Berichten aus der Literatur ein Churg-Strauss-Syndrom möglicherweise demarkieren können.
Bilder Typ
Histologie
Vergrösserung
400
Alter
45
Geschlecht
männlich
Datum
Ersteintrag: 11.02.2003
Update: 04.02.2024